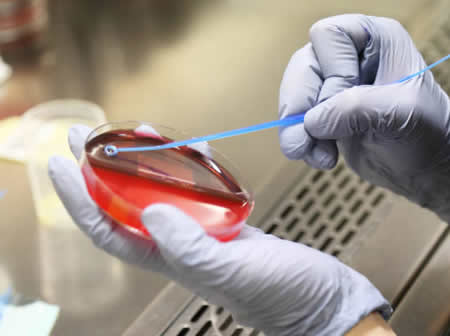
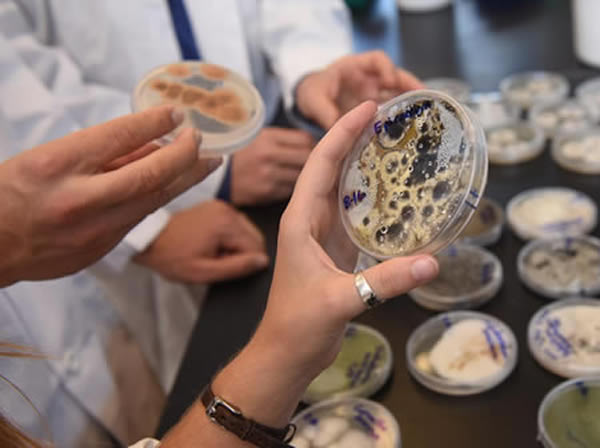

Fungal Microscopy
Microscopy and use of fungal-specific stains play important roles in diagnosis of infection by C. neoformans, P. jirovecci, Candida spp., Aspergillus spp., H. capsulatum, Blastomyces dermatitidis, Coccidioides immitis, Sporothrix schenckii, Paracoccidioides brasiliensis, and the Mucorales. Sensitivity of microscopy for diagnosis of fungal infection varies with the individual agent, the source and quality of the specimen.
- KOH mount (nail/hair/skin scraping)
- Wet mounts
- Giemsa
- Lactophenol cotton blue